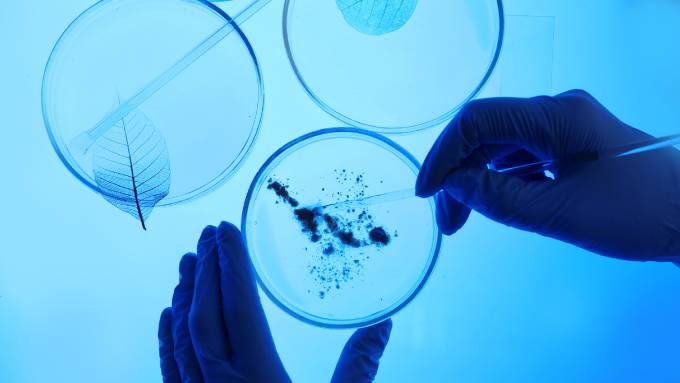
Gloves hands working on three petri dishes sitting on an illuminated surface. One dish contains a growing culture.

If you’re a science geek with a passion for biology and a soft spot for clever games, you’re in for a treat. Whether you love evolution, genetics, or ecosystems, there’s a perfect game for you. These board games to check out if you love biology will challenge your mind, spark your curiosity, and bring a bit of science to your next game night.
Pandemic: Contagion
Nothing says biology quite like wiping out humanity with a deadly pathogen. Unlike the original cooperative Pandemic, Pandemic: Contagion puts you in the role of a virus racing to infect the globe. Players compete to outsmart rival diseases by mutating, spreading, and wreaking havoc on humanity. It’s an apocalyptic thrill ride, but don’t expect a biology course in a box.
Contagion won’t teach you about avoiding common cell culture dish mistakes—players can readily assume that all possible mistakes have already happened to create the game’s apocalyptic setting. What you will get is a strategic battle to become the most devastating disease on the map.
Genotype: A Mendelian Genetics Game
Step into Gregor Mendel’s metaphorical lab coat with Genotype, a beautifully designed genetics game. You’ll breed pea plants, study inheritance, and bid on tools to improve your experiments. The gameplay brings Punnett squares and Mendelian laws to life, blending science with strategy in a way that feels organic and rewarding.
Fans of logic puzzles or anyone wanting to play with science concepts will find this one irresistible. Bonus points if you already have solid know-how about dominant and recessive traits—it’ll give you an edge.
Wingspan
There’s something magical about the award-winning Wingspan, a game where players attract and care for birds in their carefully crafted ecosystems. It’s less about hardcore biology and more about celebrating the beauty of nature’s diversity. Each species is thoroughly researched and has unique traits, from migratory patterns to egg-laying capacities—all represented by gorgeous artwork.
This is a game for bird lovers, conservationists, or anyone who enjoys subtly educational experiences paired with clever mechanics. Wingspan is proof that biology isn’t limited to labs or Petri dishes—sometimes it takes flight.
The Fox Experiment
Ever heard of the famous Russian fox domestication experiment? The Fox Experiment takes that real-life science and transforms it into charming game mechanics. Players breed foxes, selecting traits to create the friendliest or most trainable animals. Along the way, you’ll encounter natural selection, genetic trade-offs, and a sense of awe for the power of evolution.
It’s a perfect mix of science and storytelling, wrapped in an accessible, family-friendly package. Players might even come away with a deeper appreciation for the science behind domestication.
Biology has inspired some of the most imaginative and thought-provoking board games out there. Whether it’s evolving foxes, breeding pea plants, or unleashing a devastating virus, these games combine fun with fascinating science themes. The next time you’re looking for board games to check out as a biology geek, consider adding one of these to your collection. Who says science can’t be a part of game night?
Leave a Reply